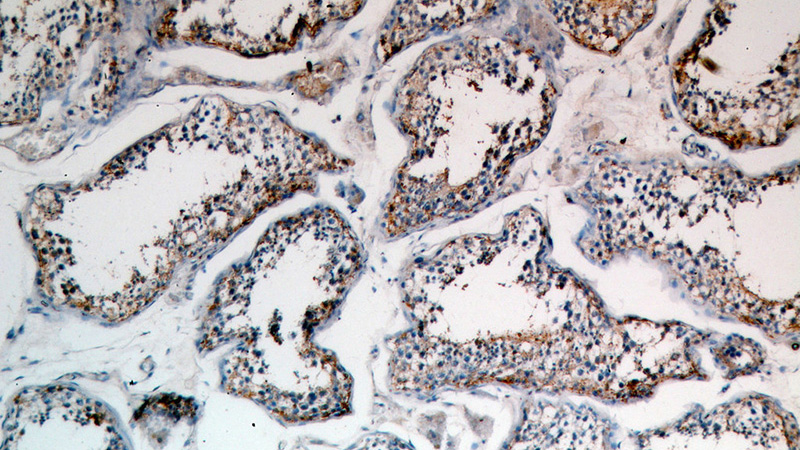
Immunohistochemical of paraffin-embedded human testis using Catalog No:111150(GPX5 antibody) at dilution of 1:50 (under 10x lens)

-
Product Name
GPX5 antibody
- Documents
-
Description
GPX5 Rabbit Polyclonal antibody. Positive IHC detected in human testis. Positive WB detected in human testis tissue, mouse liver tissue. Observed molecular weight by Western-blot: 25kd
-
Tested applications
ELISA, WB, IHC
-
Species reactivity
human; other species not tested.
-
Alternative names
GPX5 antibody; GSHPx 5 antibody; Glutathione peroxidase 5 antibody; GPx 5 antibody; EGLP antibody
-
Isotype
Rabbit IgG
-
Preparation
This antibody was obtained by immunization of Peptide (Accession Number: NM_001509). Purification method: Antigen affinity purified.
-
Clonality
Polyclonal
-
Formulation
PBS with 0.02% sodium azide and 50% glycerol pH 7.3.
-
Storage instructions
Store at -20℃. DO NOT ALIQUOT
-
Applications
Recommended Dilution:
WB: 1:200-1:2000
IHC: 1:20-1:200
-
Validations

human testis tissue were subjected to SDS PAGE followed by western blot with Catalog No:111150(GPX5 antibody) at dilution of 1:200
Immunohistochemical of paraffin-embedded human testis using Catalog No:111150(GPX5 antibody) at dilution of 1:50 (under 10x lens)

Immunohistochemical of paraffin-embedded human testis using Catalog No:111150(GPX5 antibody) at dilution of 1:50 (under 40x lens)
-
Background
GPX5 belongs to the glutathione peroxidase family. GPX5 protects cells and enzymes from oxidative damage, by catalyzing the reduction of hydrogen peroxide, lipid peroxides and organic hydroperoxide, by glutathione. Catalytic the reaction: 2 glutathione + H2O2 = glutathione disulfide + 2 H2O. GPX5 constitute a glutathionine peroxidase-like protective system against peroxide damage in sperm membrane lipids.
-
References
- Vilagran I, Yeste M, Sancho S, Castillo J, Oliva R, Bonet S. Comparative analysis of boar seminal plasma proteome from different freezability ejaculates and identification of Fibronectin 1 as sperm freezability marker. Andrology. 3(2):345-56. 2015.
- Vilagran I, Castillo-Martín M, Prieto-Martínez N, Bonet S, Yeste M. Triosephosphate isomerase (TPI) and epididymal secretory glutathione peroxidase (GPX5) are markers for boar sperm quality. Animal reproduction science. 165:22-30. 2016.
Related Products / Services
Please note: All products are "FOR RESEARCH USE ONLY AND ARE NOT INTENDED FOR DIAGNOSTIC OR THERAPEUTIC USE"
